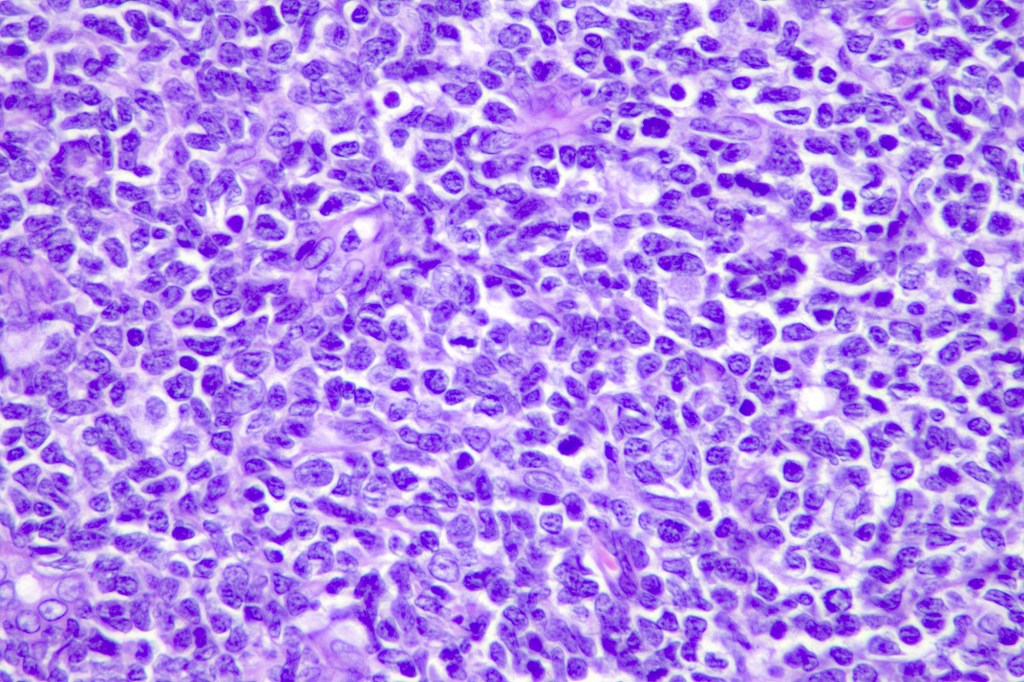
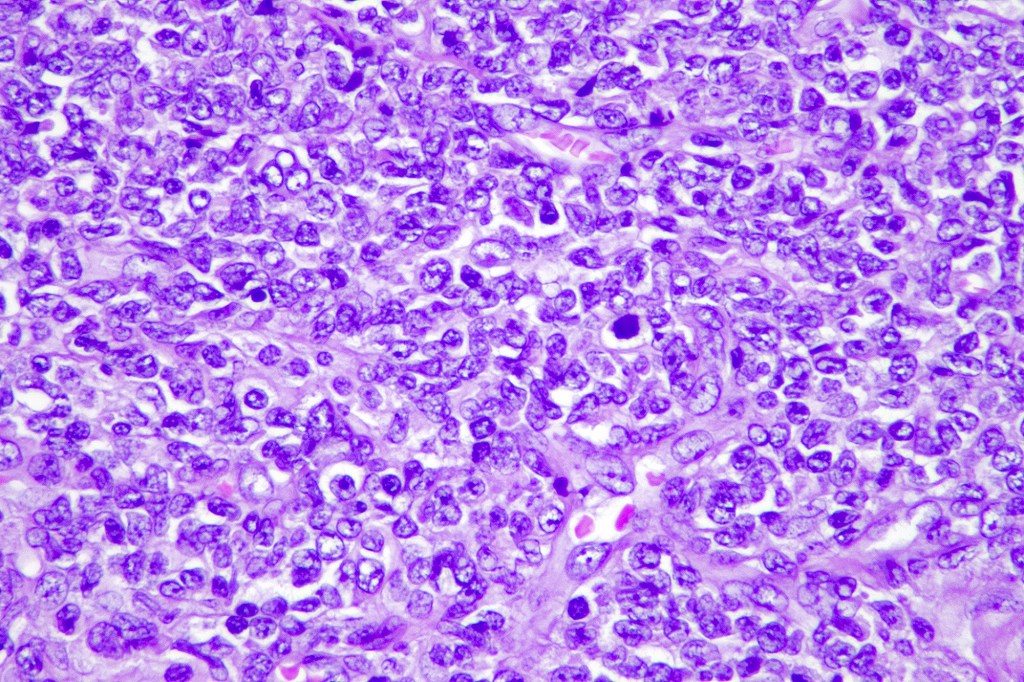
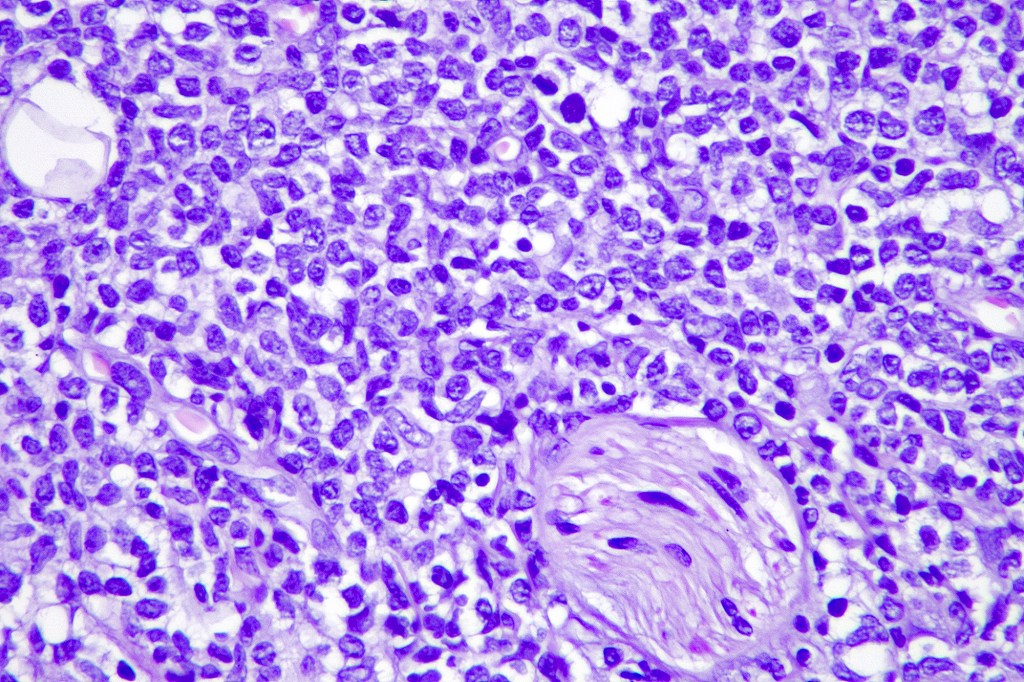
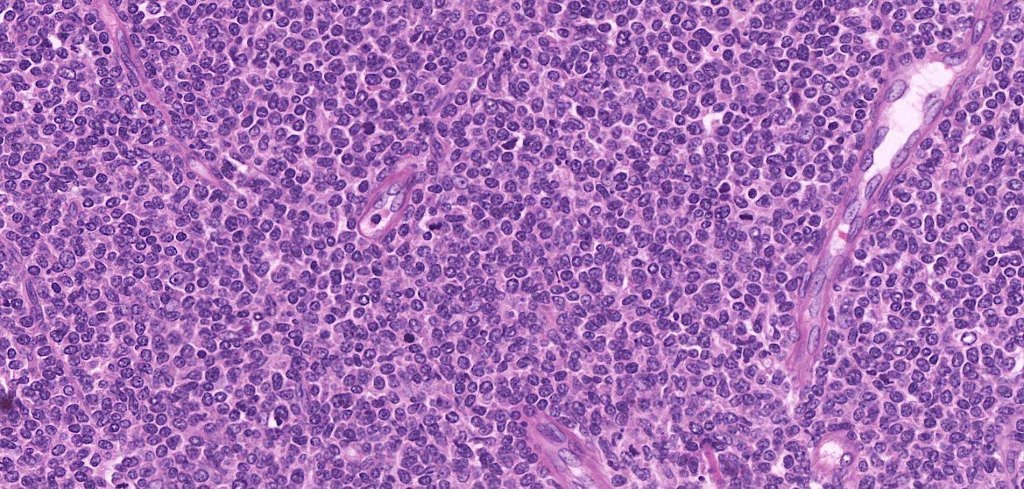
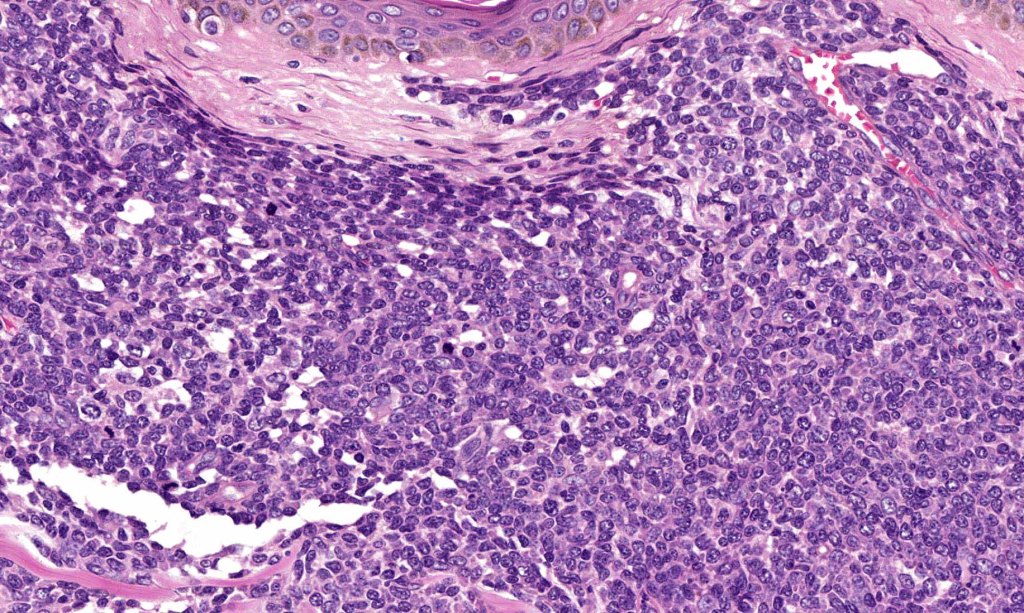
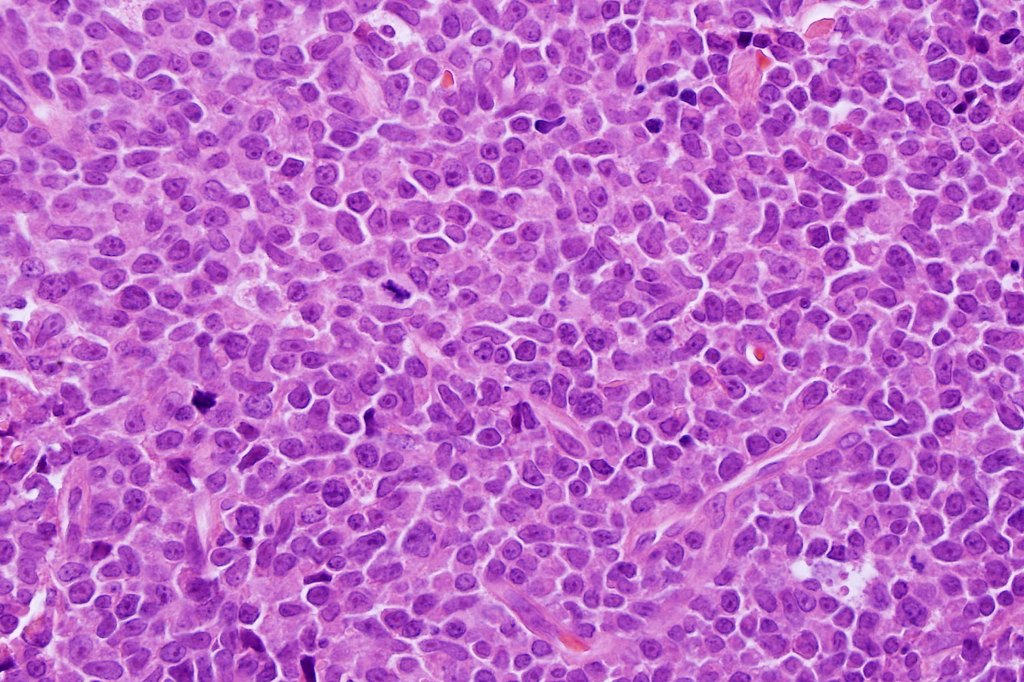
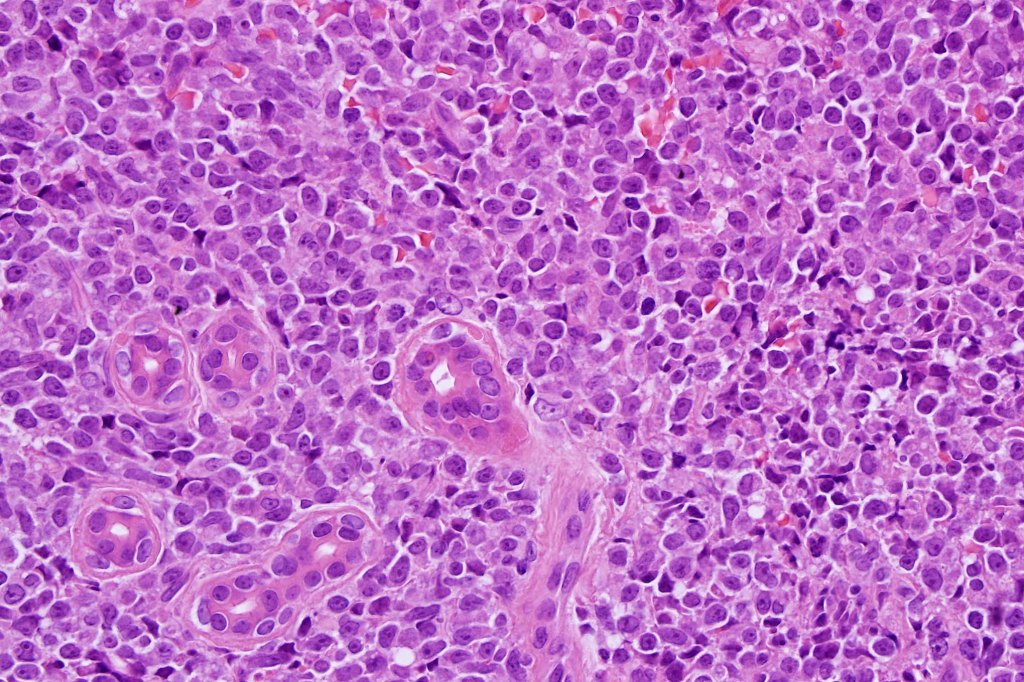
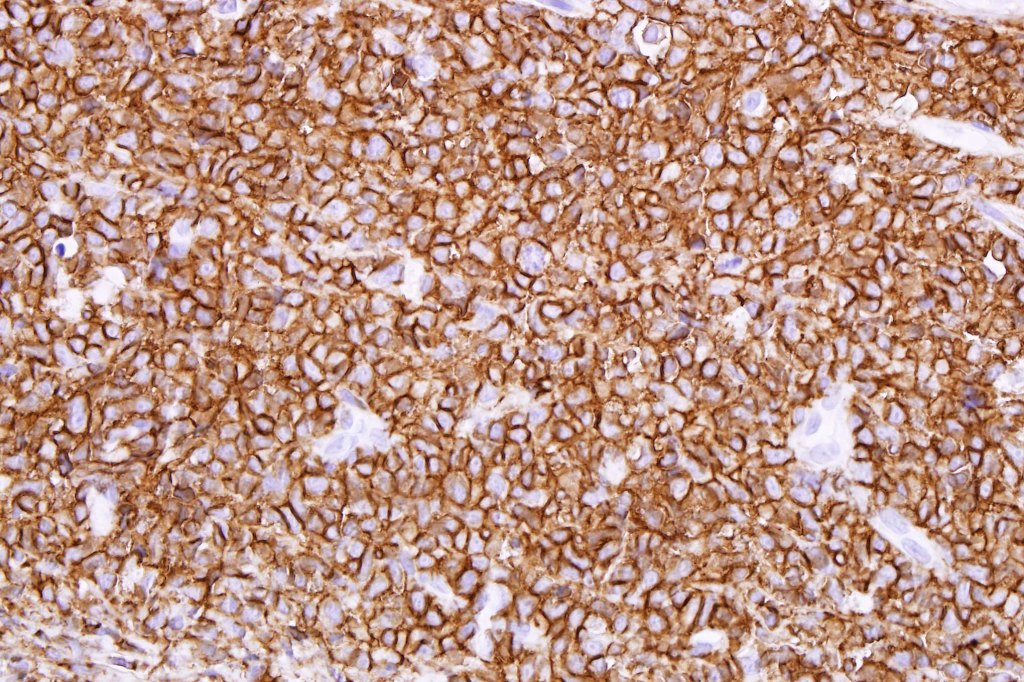

Clinical features
•Very rare aggressive acute leukemia
•Very commonly affects the skin in addition to the blood and bone marrow; also, lymph nodes & spleen
•B symptoms
•Mostly affects the elderly
•3M:1F
•Head, trunk & extremities
•Bruise-like or erythematous maculopapular lesions, nodules or plaques
•Associations with myelodysplastic syndrome, myelomonocytic leukemia or AML





Histological features
. No epidermal involvement
. Dermal +/- subcutaneous fat infiltrate
. No angioinvasion or angiodestruction
. Monotonous blast cells with gray-blue cytoplasm & irrregular vesicular nuclei with prominent nucleoli
. CD4, CD43, CD56, CD123, CD303, TCF4 & TCL1 +ve
. Variable CD68, CD7, CD33 & TdT +ve
. CD34, MNDA, lysozyme & myeloperoxidase -ve.
. Marked ki67 expression
. Germline B cell and T cell receptor genes

Differential diagnosis
AML & chronic myeloid leukemia can be distinguished by the presence of myeloid markers although distinction can sometimes be very difficult. If too much attention is given to the plasmacytoid morphology, a plamsa cell tumor may be readily excluded with IHC.
Leave a comment